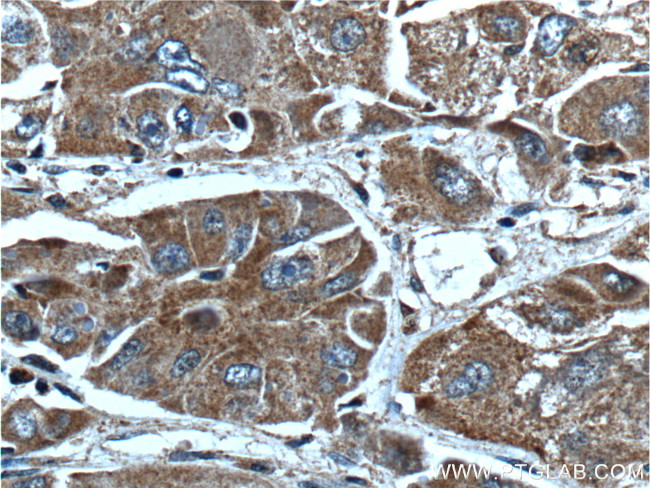
AKR7A2 Antibody in Immunohistochemistry (Paraffin) (IHC (P))
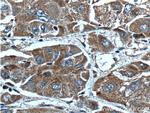
AKR7A2 Antibody in Immunohistochemistry (Paraffin) (IHC (P))

Search
Proteintech
AKR7A2 Polyclonal Antibody
{{$productOrderCtrl.translations['antibody.pdp.commerceCard.promotion.promotions']}}
{{$productOrderCtrl.translations['antibody.pdp.commerceCard.promotion.viewpromo']}}
{{$productOrderCtrl.translations['antibody.pdp.commerceCard.promotion.promocode']}}: {{promo.promoCode}} {{promo.promoTitle}} {{promo.promoDescription}}. {{$productOrderCtrl.translations['antibody.pdp.commerceCard.promotion.learnmore']}}
产品信息
10730-1-AP
种属反应
已发表种属
宿主/亚型
分类
类型
抗原
偶联物
形式
浓度
规格
纯化类型
保存液
内含物
保存条件
运输条件
产品详细信息
Immunogen sequence: RAFLERGHT ELDTAFMYSD GQSETILGGL GLGLGGGDCR VKIATKANPW DGKSLKPDSV RSQLETSLKR LQCPQVDLFY LHAPDHGTPV EETLHACQRL HQEGKFVELG LSNYASWEVA EICTLCKSNG WILPTVYQGM YNATTRQVET ELFPCLRHFG LRFYAYNPLA GGLLTGKYKY EDKDGKQPVG RFFGNSWAET YRNRFWKEHH FEAIALVEKA LQAAYGASAP SVTSAALRWM YHHSQLQGAH GDAVILGMSS LEQLEQNLAA TEEGPLEPAV VDAFNQAWHL VAHECPNYFR (60-359 aa encoded by BC007352)
靶标信息
AKR7A2 is aldo-keto reductases, which are involved in the detoxification of aldehydes and ketones.
仅用于科研。不用于诊断过程。未经明确授权不得转售。
生物信息学
蛋白别名: 2-carboxybenzaldehyde reductase; AFB1 aldehyde reductase 1; AFB1-AR 1; aflatoxin aldehyde reductase; Aflatoxin B1 aldehyde reductase member 2; aflatoxin beta1 aldehyde reductase; akr7a2; Aldoketoreductase 7; epididymis secretory sperm binding protein Li 166mP; HEL-S-166mP; SSA reductase; Succinic semialdehyde reductase; synonyms: AFAR1; unnamed protein product
基因别名: 0610025K21Rik; AFAR; AFAR1; AFB1-AR1; AKR7; AKR7A2; Akr7a5
UniProt ID: (Human) O43488, (Mouse) Q8CG76
Entrez Gene ID: (Human) 8574, (Mouse) 110198